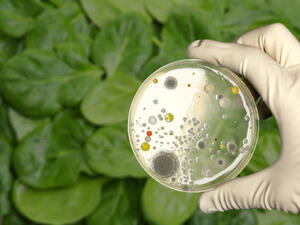
Romaine lettuce (Shutterstock)

ALBAWABA - As millions of muslims across the globe await the arrival of Eid al-Adha, an Egyptian astronomical research institute revealed that the crescent moon of the month of Dhu al-Hijjah 1446 AH will be sighted on the dawn of Tuesday, May 27. The research institute adds that the moon will be visible in Cairo's skies for a total of 47 minutes after sunset. On the contrary, the moon will ...